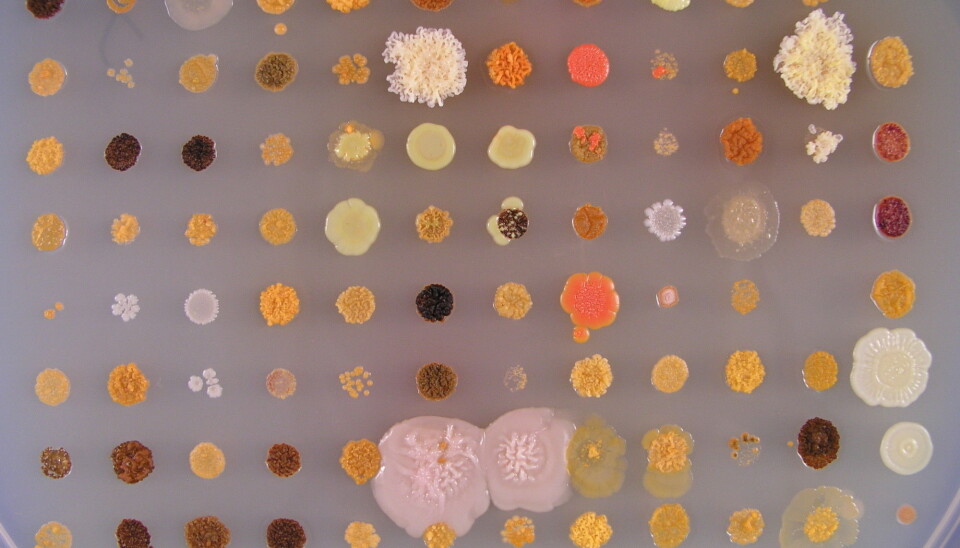

An article from Norwegian SciTech News at SINTEF
Bacteria from the sea join the fight against cancer and infections
Norwegian scientists are opening the gates of nature’s secret medicine factories, with the aim of giving us new weapons against cancers and resistant bacteria.
For decades, bacteria have served society by producing antibiotics – the chemical compounds that can cure infectious diseases. However, it is possible that many natural microorganisms carry the recipes for the medicines of the future hidden in their genetic material, without this part of their genetic code being activated or “switched on”.
But now, biotechnologists from SINTEF and NTNU are developing technology that will make it easier to find – and exploit – these hidden and unutilised medicine factories in bacteria that exist in the natural environment. The hunt will concentrate on marine bacteria, and is one of the projects run by the new Norwegian Centre for Digital Life.
“Our aim is to identify novel compounds that are capable, for example, of killing cancer cells or antibiotic-resistant bacteria. The technology that we are developing will reduce the time taken to search for these and to make the production process more efficient,” says Alexander Wentzel, a senior scientist at SINTEF.
Focus on cryptic genetic material
“Microorganisms” is the general term used to cover bacteria, fungi and yeasts. Bacteria are so small that there is room for several billion of them in a millilitre of liquid feed.

When the world discovered microorganisms that were capable of creating substances that inhibit infections, the natural properties of these organisms were at the centre of focus. The selected organisms were cultivated to produce chemical compounds that could be isolated and had already been used to fight other microorganisms in nature’s own food-bowl.
However, in the hope of developing new medicines to fight cancer, and new antibiotics that act on resistant bacteria, scientists and the pharmaceutical industry have now begun to interest themselves in the genetic material that is NOT activated when bacteria are cultivated in the laboratory.
“Switched-off” microbial genes could be used to create useful bioactive substances that are unknown today. However, until now it has been very laborious to explore this genetic information, so scientists have been forced to search through a small number of genes at a time. “This is where our technology can be of help,” says Wentzel.
Searching through many samples at a time
The technology will be developed in the course of the four-year “INBioPharm” project, which is being financed by the Research Council of Norway to the tune of NOK 27.5 million. According to Wentzel, the new techniques will enable scientists to search for useful substances simultaneously in a large number of samples. They should also result in production yields that will be high enough to enable the potential of these substances as future products to be evaluated.

To put it simply, the scientists will “clip out” genetic material from a large number of microorganisms before they transfer their DNA to cultivable bacteria; organisms whose characteristics have already been studied and will be optimized by the researchers in the INBioPharm project. The alterations will enable these organisms to switch on production of new substances that cannot be produced in the microorganism from which the DNA has been extracted.
With the aid of systems biology and synthetic biology (see fact-box), the project will develop the microorganisms in a way which, when they are cultivated, will produce small test quantities of all the possible products, and later, enable mass-production of the most promising substances.
Cooperation among researchers with different scientific backgrounds, with access to advanced laboratories, is essential to the development of such organisms. Besides SINTEF and NTNU, which are the main partners, a number of international labs are involved in the project.
Non-cultivable organisms come in from the cold
Until now, all medicine that has its origins in microorganisms has been based on organisms that can be cultivated.
“However, up to 99 per cent of all the microorganisms found in nature cannot be cultured in the laboratory. The aim of our project is to utilise also the genetic material from these organisms in our search for new products,” says Wentzel.
According to the SINTEF scientist, there is a significant likelihood that hidden in this huge pool of microorganisms, there exists “switched-off” genetic material that could produce chemicals that possess hitherto unknown structures and activities.
“It is not least for this reason that this project is so exciting. We may well find new medicines that could mean the difference between life and death for large numbers of patients in the future.”
-------------------------------------
Read the Norwegian version of this article at forskning.no